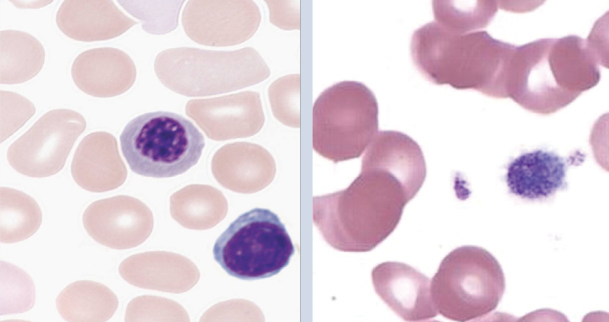
High-Efficiency & Reliable Performance

CH8300
Automatic Hematology Analyzer

CH8300
Automatic Hematology Analyzer
3-Part Hematology Analyzer
Small Samples, Lab-Grade Accuracy

Throughput: 70T/H
21 reportable parameters + 2 research parameters
Only 9μL blood sample is required
Specially developed for users with small sample volumes
10.4-inch capacitive touch screen, intuitive guided interface
Drastically Improve Usability and Operability
High-Efficiency & Reliable Performance
70 tests/hour throughput to quantify efficiency
Cyanide-free method + multiple histograms prevent error analysis

Intelligent Diagnostics System
Streamlined workflow from sample preparation to result interpretation
Convenient access lyse placement and flexible reagent tube options
10.4-inch capacitive touch screen
Intelligent Diagnostics System
Only 11.5 μL of blood is required to obtain comprehensive hematological information
Provides detailed reports with 23 parameters
Intelligent Diagnostics System
Requires only 3 blood reagents
70% less reagent consumption than competitors
Supports both open & closed systems
Redefining Blood Diagnostics – One Drop at a Time
